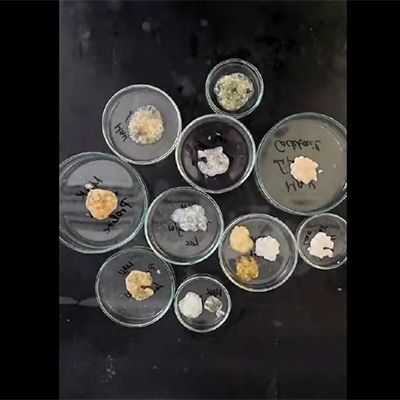

Green Chemical Engineering Network towards upscaling sustainable processes
(CA18224) – GREENERING
About GREENERING
Green Chemical Engineering Network towards upscaling sustainable processes (CA18224) – GREENERING, is project (Action) funded by COST (European Cooperation in Science and Technology).
Work Structure
The research activities coordinated in GREENERING are focused on the successful accomplishment of the objectives proposed. The Action will achieve its scientific goals through 4 inter-related Working Groups (WGs), each one with its aim, objectives and tasks foreseen to achieve specific milestones.
Activities
Short Term Scientific Missions (STSMs) are short term institutional visits aimed to support individual mobility, strengthen existing networks and foster collaboration between COST Action Participants.
ITC grants are Conference Grants for Inclusiveness Target Countries (ITC) funded by COST.
STSM holders and their projects
In the first 3 years CA 18224 GREENERING has funded and supported many STSMs
COST (European Cooperation in Science and Technology) is a funding agency for research and innovation networks. COST Actions help connect research initiatives across Europe and enable scientists to grow their ideas by sharing them with their peers. This boosts their research, career and innovation.
Action Details
- MoU - 041/19
- CSO Approval date - 04/06/2019
- Start of Action - 14/10/2019
- End of action- 13/04/2024
Former end of action - 13/10/2023